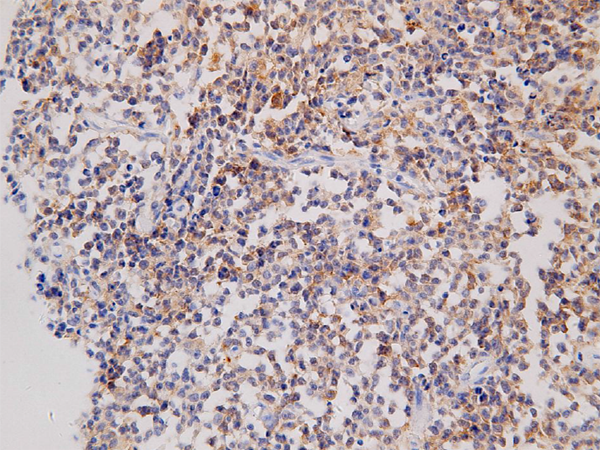

中文名稱:小鼠抗CSTB單克隆抗體
|
Background: |
The cystatin superfamily encompasses proteins that contain multiple cystatin-like sequences. Some of the members are active cysteine protease inhibitors, while others have lost or perhaps never acquired this inhibitory activity. There are three inhibitory families in the superfamily, including the type 1 cystatins (stefins), type 2 cystatins and kininogens. This gene encodes a stefin that functions as an intracellular thiol protease inhibitor. The protein is able to form a dimer stabilized by noncovalent forces, inhibiting papain and cathepsins l, h and b. The protein is thought to play a role in protecting against the proteases leaking from lysosomes. Evidence indicates that mutations in this gene are responsible for the primary defects in patients with progressive myoclonic epilepsy (EPM1). One type of mutation responsible for EPM1 is the expansion in the promoter region of this gene of a CCCCGCCCCGCG repeat from 2-3 copies to 30-78 copies. |
|
Applications: |
ELISA, WB, IHC |
|
Name of antibody: |
CSTB |
|
Immunogen: |
Fusion protein of human CSTB |
|
Full name: |
cystatin B |
|
Synonyms: |
PME; ULD; CST6; EPM1; STFB; CPI-B; EPM1A |
|
SwissProt: |
P04080 |
|
IHC positive control: |
Human lymphoma |
|
IHC Recommend dilution: |
40-200 |
|
WB Predicted band size: |
11 kDa |
|
WB Positive control: |
HEK293 whole cell lysate |
|
WB Recommended dilution: |
500-2000 |

購物車
購物車 幫助
幫助
 021-54845833/15800441009
021-54845833/15800441009
